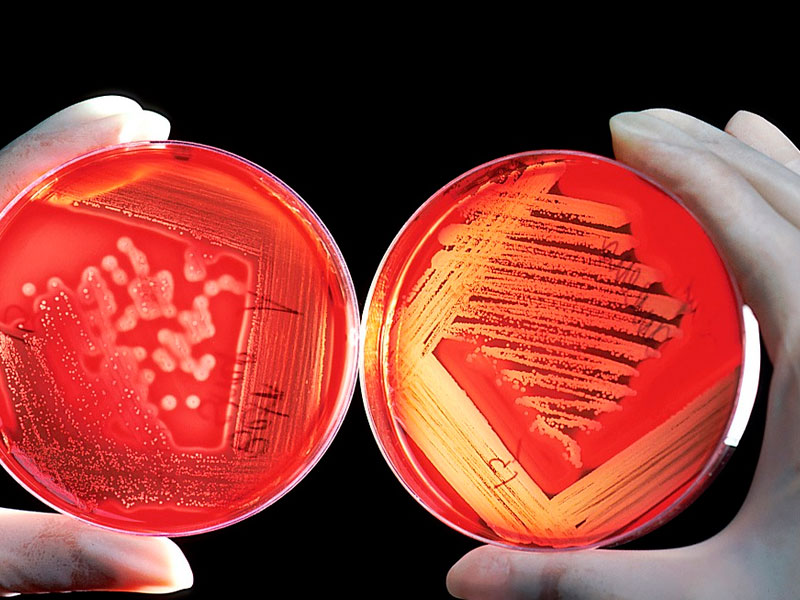

#Россия 30.11. Главное – аналитический портал ПОЛИТ.РУ

 Сергей Лавров, глава МИД РФ © фото ООН
Сергей Лавров, глава МИД РФ © фото ООН Главная новость
Глава МИД России Сергей Лавров заявил о том, что вопрос вхождения Крыма в состав России закрыт окончательно. Он добавил, что речь идет о «свободном, демократическом волеизъявлении жителей Крыма, которые сделали осознанный выбор в пользу мира и процветания», пишет ТАСС со ссылкой на интервью в итальянской газете Libero.
«Тема закрыта раз и навсегда», — сказал Лавров, отвечая на вопрос, навсегда ли Крым останется в составе России.
Он добавил, что этот шаг – единственный возможный способ защиты интересов народа полуострова после государственного переворота на Украине в феврале 2014 года.
«Сегодня очевидно, что выраженная на референдуме воля жителей полуострова позволила им избежать ужасов гражданской войны — того, что на протяжении более трех лет киевские власти вытворяют в Донбассе», —сказал глава МИД РФ.
Крым вошел в состав России в марте 2014 года в результате проведения референдума. Тогда за воссоединение с Россией проголосовали свыше 95% жителей полуострова. Явка на референдум составила более 80%.
Страны Евросоюза, Украина и США отказались принять независимость Крыма и его присоединение к России.
Антиновость
Роскачество провело исследование состава творога 9% жирности, отправив товары 44 торговых марок на экспертизу. Проверялись 62 показателя, среди которых – наличие в продукте антибиотиков, плесени, токсичных веществ.
Кишечная палочка была обнаружена в твороге торговой марки «Буренкино» («Обнинские молочные продукты», Калужская область)и «Добрая буренка» («Саратовский молочный комбинат», Саратов).
Биопробы пищевых продуктов / pixabay.com
Биопробы пищевых продуктов / pixabay.com Дрожжи были найдены в твороге марок «Домик в деревне» (Москва), «Балтком» (Москва), «Залесский фермер» (Москва), «Милава» (Московская область), «Искренне ваш» (Тверская область) и ряд других.
Плесень найдена в продукции «Милава», «Билла», «Красная цена» (производители по всей России) и «Зорька» (Новосибирск).
Продукция, которая содержит антибиотики выше допустимой нормы – «Чабан» (Нальчик), «БМК» (Брянск), «Веселый луг».
Повышенным требованиям Роскачества, согласно экспертизе, соответствует творог следующих торговых марок: «Простоквашино», «Президент», «Савушкин продукт», «Амка», «Снежок», «Брест-Литовск», «Томское молоко», «Томмолоко», «Белый город», «Коровка из Кореновки», «Углече Поле», «Братья Чебурашкины», «Заливные луга», «Вологжанка», «Вятушка», «Агрокомплекс», «Молочный комбинат Ставропольский», говорится в сообщении на сайте Роскачества.
Непонятная новость
В Башкирии принят региональный закон, который запрещает родителям называть детей бранными словами, указывать ранги, использовать в имени ребенка символы, цифры, знаки, кроме дефиса. Под запрет не попадает имя «Султан», пишут РИА Новости со ссылкой на представителя пресс-службы регионального парламента.
 Фишки для игры с буквами / pixabay.com
Фишки для игры с буквами / pixabay.com «При выборе родителями имени ребенка не допускается использование в его имени цифр, буквенно-цифровых обозначений, числительных, символов и не являющихся буквами знаков, за исключением знака «дефис», или их любой комбинации либо бранных слов, указаний на ранги, должности, титулы», — говорится в законе, принятом депутатами башкирского парламента Курултая.
Фамилия ребенка, по решению депутатов, определяется фамилией родителей, может присваиваться от отца и матери, если фамилии разные – то присоединением их друг к другу в любой последовательности. Двойная фамилия включает в себя дефис и не может состоять более, чем из двух слов.
Имя Султан вызвало особое внимание. В руководстве Башкирии отметили, что имя распространено в республике и не должно попадать под запрет, не смотря на то, что является титулом.
Ассорти
В Екатеринбурге Федеральная таможенная служба (ФТС) и ФСБ раскрыли схему поставок люксовой одежды в Москву, Сочи, Краснодар, Санкт-Петербург. Компания ООО «Реалма» за два года через екатеринбургский аэропорт «Кольцово» ввезла в Россию 300 тонн одежды торговых марок Christian Dior и Rosie Assoulin, в документах оформив их как нитки и ткань, пишет РБК.
Канал контрабанды был обнаружен в августе. По информации источника РБК, 11 августа екатеринбургское ООО «Реалма», пыталось провезти в Россию 405 кг брендовой одежды, задекларировав их как нитки и ткань.
 Магазин одежды / pixabay.com
Магазин одежды / pixabay.com В ФТС подтвердили возбуждение уголовного дела. Размер ущерба пока подсчитывается.
«Если предположить, что все 300 тонн были на самом деле брендированной одеждой, исходя из средней стоимости 1 кг одежды в последней партии в 300 тыс. руб., ущерб государству мог составить несколько миллиардов рублей», — сказал собеседник издания.
В самой компании отметили, что возбуждено дело по подозрению в уклонении от уплаты таможенных платежей. Совладелец «Реалмы» Евгений Курлыкин отметил, что в данный момент «коммерческая деятельность предприятия полностью парализована».
Предъявленные обвинения он отвергает.
«Вся ввезенная на таможенную территорию Таможенного союза по действующим внешнеэкономическим контрактам импортная продукция <...> подлежала обязательному таможенному контролю и прошла надлежащее таможенное оформление в уполномоченных таможенных органах», — сказал Курлыкин.
*
Пермский аэропорт сохранит старое название «Большое Савино». На открытии нового терминала аэропорта об этом сказал губернатор Максим Решетников, пишет «Коммерсант».
Новый терминал пока будет работать только с внутрироссийскими рейсами, а международные будут обслуживаться в старом терминале аэропорта.
 Проект нового терминала аэропорта Большое Савино
Проект нового терминала аэропорта Большое Савино Строительство нового терминала началось в ноябре 2015 года. Плановый срок вводы в эксплуатацию – декабрь 2017 года.
Решение о сохранении старого названия было принято жителями города в ходе интернет-голосования. Среди предлагаемых пермякам наименований были «MOLOTOV AIR», «Терминал Юрятин», «PermSky», «Мордор», «Терминал-терминал», «Терминал имени В.В. Путина».
*
Задержан координатор саратовского штаба Алексея Навального Михаил Мурыгин. Ему инкриминируют организацию незаконного массового мероприятия, сообщает «Коммерсант».
«Мне пытаются вменить организацию митинга. Хотя никакого митинга нет, и я организацией никакого митинга не занимаюсь»,— сказал задержанный.
 Михаил Мурыгин, координатор саратовского штаба Алексея Навального / © ИА "Версия-Саратов"
Михаил Мурыгин, координатор саратовского штаба Алексея Навального / © ИА "Версия-Саратов" Мурыгину грозит наказание в виде административного ареста до 10 суток.
1 декабря в Саратове планируется встреча Алексея Навального со своими сторонниками. Она должна пройти в «гайд-парке», массовое проведение мероприятий в котором не требует согласования с мэрией. Перед этим сотрудники горадминистрации уже приходили к Мурыгину, предостерегая его от нарушения закона в день встречи с Навальным, пишет FreeNews-Volga.